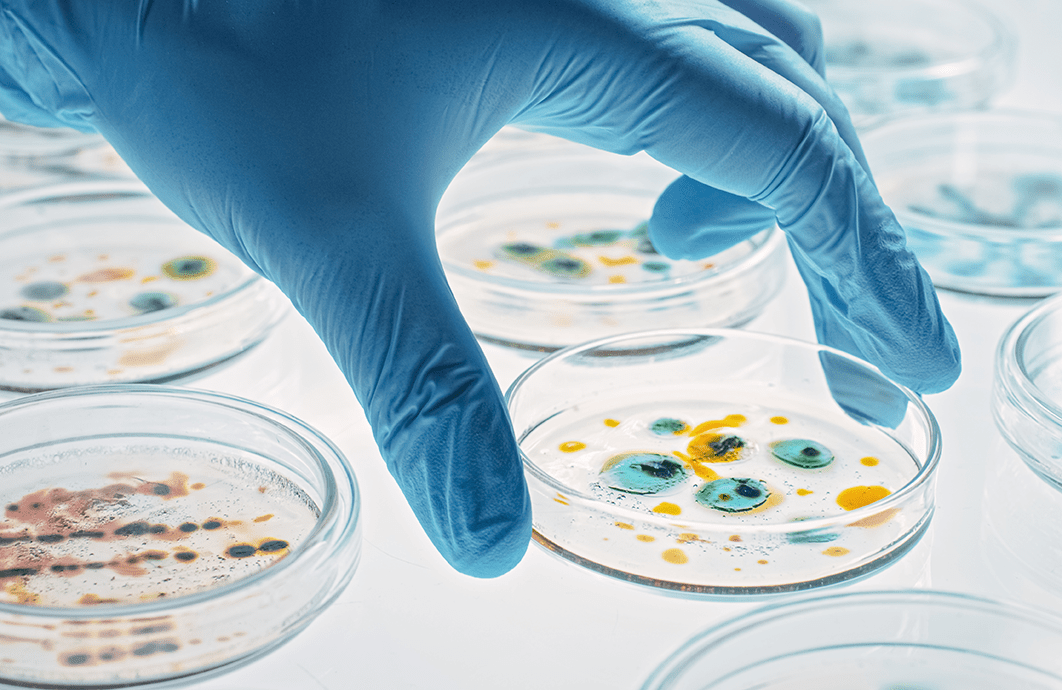
A gloved hand holds a petri dish, with other dishes in the background.

The science and practice of clinical microbiology is crucial for the detection, diagnosis, and treatment of infectious diseases. Clinical microbiologists identify viral pathogens, help ensure close surveillance of the spread of diseases, and research drug resistance. If you're interested in exploring current and emerging developments in the field of microbiology and its growing impact on patient care and public health initiatives, we've curated highlights of ADLM's resources here.

Guidance from the Academy for Diagnostics & Laboratory Medicine

Learn about experts' best practices for navigating respiratory virus diagnosis with several tests available.
Explore potential uses of procalcitonin, a protein for which utility in clinical settings and patient populations remains undefined.


Attend engaging and informative sessions on microbiology and infectious disease at ADLM 2026, the premier global laboratory medicine conference.


Featured articles

The human microbiome is a multi-dimensional and dynamic part of our physiology that plays a key role in managing health.
A practical look at how at-home blood collection works and the challenges that labs face.
On-demand webinars
Presented by top experts and industry leaders, ADLM's webinars help laboratorians stay up to date on the latest in clinical laboratory medicine and management.

-
Community-acquired pneumonia diagnosis and the impact on patient outcomes
Best practices for evaluating patients with pneumonia, the practical value of urinary antigen testing (UAT), and more.
-
Strep sleuths: Solving the pharyngitis puzzle with evidence
Delve into the diagnosis and management of pharyngitis to improve patient outcomes.
-
Current testing recommendations for viral respiratory infections
Learn about the pre-analytical factors for influenza, respiratory syncytial virus (RSV), and COVID-19.
